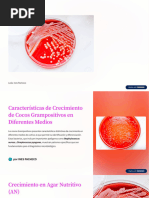

0% encontró este documento útil (0 votos)
92 vistas9 páginasGénero Staphylococcus: Características y Patología
Este documento describe el género Staphylococcus. Son cocos gram positivos que se agrupan en racimos y comprenden especies como S. aureus y S. epidermidis. Se clasifican mediante pruebas de catalasa y coagulasa. Pueden causar infecciones de la piel y del tracto respiratorio. El S. aureus es un patógeno importante que expresa numerosos factores de virulencia como toxinas y enzimas.
Cargado por
jaelDerechos de autor
© © All Rights Reserved
Nos tomamos en serio los derechos de los contenidos. Si sospechas que se trata de tu contenido, reclámalo aquí.
Formatos disponibles
Descarga como DOCX, PDF, TXT o lee en línea desde Scribd
0% encontró este documento útil (0 votos)
92 vistas9 páginasGénero Staphylococcus: Características y Patología
Este documento describe el género Staphylococcus. Son cocos gram positivos que se agrupan en racimos y comprenden especies como S. aureus y S. epidermidis. Se clasifican mediante pruebas de catalasa y coagulasa. Pueden causar infecciones de la piel y del tracto respiratorio. El S. aureus es un patógeno importante que expresa numerosos factores de virulencia como toxinas y enzimas.
Cargado por
jaelDerechos de autor
© © All Rights Reserved
Nos tomamos en serio los derechos de los contenidos. Si sospechas que se trata de tu contenido, reclámalo aquí.
Formatos disponibles
Descarga como DOCX, PDF, TXT o lee en línea desde Scribd